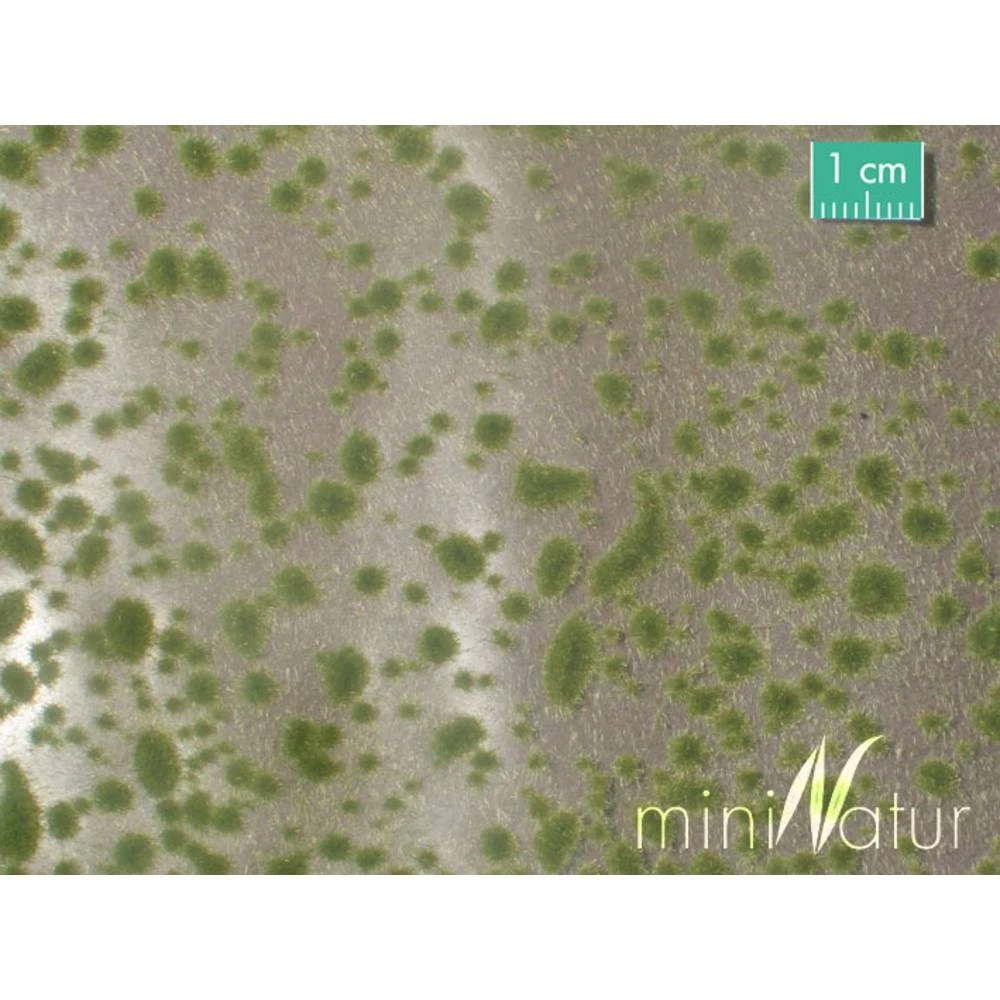

Mahovina Mininatur 747-23 Početak jeseni boja
- Kataloški br:
- 1858437 - 62
- Oznaka:
- 747-23
- EAN:
- 4048847747234
- Kataloški br:
- 1858437 - 62
- Oznaka:
- 747-23
- EAN:
- 4048847747234
Mahovina Mininatur 747-23 Početak jeseni boja
Cijena na upit

0.00 KM
Komada
Prodaja i slanje od:
Architektengruppe S71 d.o.o.
Komada

Tehničke specifikacije
Tehničke specifikacije
| Product.SubCategory | Mahovina |
| Boja | Početak jeseni boja |
| Dimenzija proizvoda, širina | 150 mm |
| Dimenzije proizvoda, dužina | 420 mm |
| Sadržaj | 38 g |
| Starosna skupina | Iznad 15 godina |
Opis
Opis
Čak i najmanji detalji zelenila čine razliku! Mali jastuci od mahovine savršeni su za izradu šumskih podova. Presvlake nanesene na plastičnu foliju mogu se ukloniti s nosača i zalijepiti ljepilom u modelni krajolik.
Ovaj tekst je strojno preveden.
Ovaj tekst je strojno preveden.
Ocjene kupaca
Ocjene kupaca
Prosječna ocjena
0.00 od 5 zvjezdica
Još nema recenzija ovog proizvoda, ali to možete promijeniti.